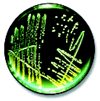

Organ
der
GD — Gesellschaft für Dermopharmazie e.V.
| Home |
| Ausgabe: 1/2016 |
| 1/2015 |
| 1/2014 |
| 1/2013 |
| 1/2012 |
| 2/2011 |
| 1/2011 |
| 1/2010 |
| 1/2009 |
| 1/2008 |
| 2/2007 |
| 1/2007 |
| 2/2006 |
| 1/2006 |
| 2/2005 |
| 1/2005 |
| 2/2004 |
| 1/2004 |
| 2/2003 |
| 1/2003 |
| 2/2002 |
| 1/2002 |
| 4/2001 |
| 3/2001 |
| 2/2001 |
| 1/2001 |
| 1/2000 |
| Weitere Links: |
| Gesellschaft für Dermopharmazie |
Ausgabe Oktober 2000
Ausgabe Oktober 2000nach oben